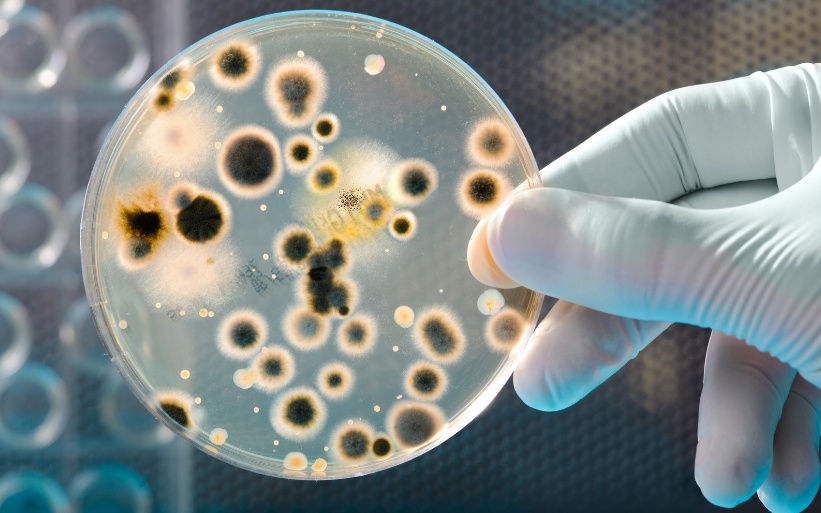

编辑:晴晨
黄梅天到了,阴雨连绵,家里衣服经常晾不干,有的衣服收起来还有一股汗泥味道,闻了又上头又刺鼻。明明是洗过的衣服,这些臭味又是哪来的呢?

某跨国日用品公司首席科学家玛丽·约翰逊表示,衣服上超过三分之二的污垢来自我们身体外部的分泌物,即汗水和皮脂。皮脂是我们皮肤表面自然分泌的油性蜡状物质,起到防护和滋润的作用。
如果在洗衣服的过程中皮脂没有洗干净的话,它就可以成为衣服(没有正确晒干)臭味来源的罪魁祸首。因为这些天然的油没有洗掉就会沉到布料的纤维中,并且它们非常黏稠,容易吸引污垢,一来二去,就为细菌真菌的繁殖提供了一个绝佳的“培养皿”。如果衣服长期处在潮湿的状态下,细菌滋生和真菌滋生就会释放大量气体,因此衣服会出现异味。
除了有味道外,微生物的滋生对身体健康还有一定影响。衣服在潮湿环境中滋生的细菌或真菌吸入人体,会导致呼吸道感染引发炎症。另外,有些细菌或真菌的病原体对人体有致敏的作用,因为这些细菌或真菌的蛋白,对呼吸道或皮肤来说都属于过敏原,可能会使人体产生一系列过敏反应,比如常见的哮喘、荨麻疹等。

既然阴干的衣服容易滋生细菌,有哪些办法可以避免呢?
使用消毒剂。事实上,使用消毒剂能够去除一部分细菌或者真菌,但一定要严格参照使用说明适量放入。即便使用了消毒剂,也要在太阳光下尽快将衣服晒干,这样才能避免微生物大量繁殖。
加热清洗。让衣服在56—75℃的水中保持30分钟以上,也能起到比较好的杀菌作用。
机器烘干。雨天多或潮湿的地区,不妨考虑买一台带杀菌功能还可烘干的洗衣机,或者买一台专用来烘干衣服的烘干机。
需要提醒的是,很多人以为换季的衣服洗干净后收好,来年就可以拿出来直接穿,这也是一种错误做法。衣服长时间存放会因为空气流通不足而滋生螨虫,还可能出现病菌或过敏原,直接穿上它,容易导致皮肤过敏,甚至会出现荨麻疹等。因此,即使是洗干净的换季衣服,再拿出来穿时也别忘记清洁晾晒,让它们充分接受阳光的“洗涤”。
参考来源:中国家庭报、科普中国、澎湃新闻、澎湃新闻

